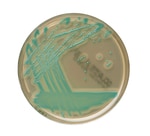

Search
- Home
- Shop All Products
- Chromogenic Plates
Brilliance™ Listeria
Grow and differentiate Listeria monocytogenes and Listeria spp. in food samples using Thermo Scientific™ Brilliance™ Listeria with the Precis method (Listeria One Broth) to achieve results 48 hour earlier than traditional methods.
